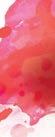

The Blade reports from the border, PAGE 14



![]()



The Blade reports from the border, PAGE 14




















































































































































































ADDRESS PO Box 60664
Washington DC 20039
PHONE
202-747-2077
news@washblade.com
INTERNET washingtonblade.com
PUBLISHED BY Brown Naff Pitts Omnimedia, Inc.
PUBLISHER
LYNNE J. BROWN
lbrown@washblade.com ext. 8075
EDITORIAL
EDITOR
KEVIN NAFF
knaff@washblade.com ext. 8088
SR. NEWS REPORTER
LOU CHIBBARO JR. lchibbaro@washblade.com ext. 8079
WHITE HOUSE CORRESPONDENT CHRIS KANE
ckane@washblade.com extg 8083
INTERNATIONAL NEWS EDITOR
MICHAEL K. LAVERS mlavers@washblade.com ext. 8093
POP CULTURE REPORTER
JOHN PAUL KING PHOTO EDITOR
MICHAEL KEY mkey@washblade.com ext 8084
CONTRIBUTING WRITERS
DANIEL ITAI, EDICIÓN CIENTONCE, QUORUM, WDG, STEPHANIE MONDRAGÓN, ISAAC AMEND , TINASHE CHINGARANDE, DUNIA ORELLANA, REPORTAR SIN MIEDO, PETER ROSENSTEIN, MARK LEE, LATEEFAH WILLIAMS, KATE CLINTON, KATHI WOLFE, ERNESTO VALLE, YARIEL VALDÉS GONZÁLEZ, PHILIP VAN SLOOTEN, KATLEGO K. KOLANYANEKESUPILE, KAELA ROEDER, TREMENDA NOTA, ALBERTO J. VALENTÍN, MAYKEL GONZÁLEZ VIVERO, ORGULLO LGBT. CO, ESTEBAN GUZMAN, ANDRÉS I. JOVÉ RODRÍGUEZ
CREATIVE DESIGN/PRODUCTION
AZERCREATIVE.COM
SALES & ADMINISTRATION
DIRECTOR OF SALES & MARKETING
STEPHEN RUTGERS srutgers@washblade.com ext. 8077
SR. ACCT. EXECUTIVE
BRIAN PITTS
bpitts@washblade.com ext. 8089
CLASSIFIED ADVERTISING/ADMINISTRATION
PHILLIP G. ROCKSTROH prockstroh@washblade.com ext. 8092
NATIONAL ADVERTISING
RIVENDELL MEDIA
212-242-6863; sales@rivendellmedia.com
For distribution,




THE WHARF ICE RINK ON TRANSIT PIER IS OPEN THROUGH FEBRUARY
During the colder months, enjoy one of the coolest spots on the waterfront: The Wharf Ice Rink. Come to Transit Pier and lace up your skates—bring your own or rent some rink-side. The Wharf Ice Rink is open every Wednesday to Sunday through the end of February.
Ice skate with your family and friends and join us for our on-the-ice events including Curling & Cocktails and Rock the Rink with the Washington Capitals.
CURLING & COCKTAILS | EVERY WEDNESDAY, 7PM, 8PM, 9PM ROCK THE RINK | SATURDAY, FEBRUARY 22, 2PM-5PM



Leaders of local advocacy groups testify at Council oversight hearing
By LOU CHIBBARO JR. | lchibbaro@washblade.com
Officials with five local LGBTQ community organizations and officials with another four groups that also provide services for LGBTQ D.C. residents testified before a D.C. Council performance oversight hearing on Jan. 30 that examined the work of Mayor Muriel Bowser’s Office of LGBTQ Affairs.
The hearing, which also examined the Mayor’s Office of Veterans Affairs and Office of Religious Affairs, was called by D.C Council member Brianne Nadeau (D-Ward 1) in her role as chair of the Council’s Committee on Public Works and Operations.
Nearly all the witnesses praised what they called the LGBTQ Affairs Office’s longstanding support for the D.C. LGBTQ community through a wide range of services and programs and what they called the “dedicated” work of its director, Japer Bowles.
Officials with at least four of the LGBTQ organizations, including the D.C. LGBTQ Budget Coalition and the LGBTQ youth advisory group SMYAL, expressed concern over what they called long delays in funding from grants awarded to LGBTQ and LGBTQ supportive groups by the Office of LGBTQ Affairs.
Several of the witnesses, including Kimberley Bush, executive director of the D.C. LGBTQ+ Community Center, who submitted written testimony, said the funding delays were being caused by other D.C. government agencies that administer city grant programs.
Bush stated that the delays in funding for the LGBTQ+ Community Center for a $50,000 Community Development Grant and a $50,000 Violence Prevention and Response Team (VPART) Grant, “by no fault” of the LGBTQ Affairs Office, “caused extraordinary and substantial financial strain on our cash flow.”
Heidi Ellis, coordinator of the D.C. LGBTQ+ Budget Coalition, raised a related issue of concern that the mayor’s office, based on “shifting priorities,” sometimes significantly lowers the level of grant funds from the Office of LGBTQ Affairs to community-based LGBTQ grant recipients.
Ellis and other witnesses at the hearing referred to this as “yo-yo funding and shifting of mayoral priorities” that they said makes it difficult for LGBTQ groups receiving city

grants to continue their programs and services. In his own testimony, and in response to questions from Nadeau and D.C. Council member Zachary Parker (D-Ward 5), who is the Council’s only gay member, LGBTQ Affairs Office Director Bowles said some of the delays in grant payments were due to a vacancy in the office staff position that administers the grants, which he said has now been filled.
Among other things, Bowles said the complexity of the grant approval process, which he said involves “different layers of funding decisions” by other D.C. government offices, also has caused some delays. He said that despite what he called some of his office’s challenges, the office continues to expand its role in supporting the local LGBTQ community.
“With Mayor Bowser’s leadership and support, I’m proud to have led efforts that transformed the office,” he stated in his testimony. “We secured the bid for WorldPride 2025, expanded our grant programs from $75,000 to over $6 million, revamped our community engagement strategy, and much more,” he said.
“These changes have had a direct impact on addressing public safety concerns and providing housing and support to vulnerable residents,” he added. According to Bowles, his office’s LGBTQIA+ Community Development Grant program saw a record expansion in fiscal year 2024, with more than $1 million awarded to 29 community-based organizations. (The Washington Blade has been a recipient of a grant that funds a journalism fellow who reports on local LGBTQ
The Comings & Goings column is about sharing the professional successes of our community. We want to recognize those landing new jobs, new clients for their business, joining boards of organizations and other achievements. Please share your successes with us at comingsandgoings@ washblade.com.
Congratulations to Ryan Levi on assuming the presidency of the D.C. chapter of the National Lesbian and Gay Journalists Association (DCNLGJA).
“I’m incredibly excited to take on this new leadership role with an organization full of incredible journalists,” Levi said. “In these
By PETER ROSENSTEIN
uncertain and challenging times for many in our queer and trans community, I hope NLGJA can continue to be a space for queer and trans D.C. journalists to connect with their peers, find support, grow in their careers, and build community.”
Levi’s background includes being a reporter and producer with Tradeoffs Washington, D.C., where he reported and produced podcast episodes for the national nonprofit health policy news organization. Topics included ransomware attacks on hospitals, bias and AI in health care, and bringing Medicaid to incarcerated people. He was the lead reporter on The Fifth
community news.)
“These grants support a wide range of LGBTQIA+ dedicated initiatives, including mental health counseling, youth leadership, and arts and culture projects,” he said. “As part of our broader advocacy efforts, we secured funding for the Violence Prevention and Response Team, which provides trauma-informed legal and counseling services to survivors of hate-based incidents.”
Among the LGBTQ officials who praised Bowles’s work and the LGBTQ Affairs Office while raising concerns about the office’s ability to carry out its ambitious programs was Vincent Slatt, chair of the D.C. Advisory Neighborhood Commission’s Rainbow Caucus. The caucus currently consists of 38 out LGBTQ ANC commissioners based in all eight D.C. wards.
Slatt called on Mayor Bowser and the D.C. Council to increase the number of full-time staff members for the LGBTQ Affairs Office from its current six staff members to 10 or 11 full-time staffers.
“To address these challenges, we strongly recommend increasing the office’s staff to match the scale of its responsibilities and the growing needs of our community,” Slatt told the committee. He added that the office’s current “chronic staffing and budget shortage disparities will become even more concerning in light of the recent and anticipated homophobic and transphobic attacks expected from the White House and Congress.”
The other LGBTQ community witnesses who praised the LGBTQ Affairs Office’s overall work while expressing concern over delays in grant funding were Rebecca York, SMYAL’s director of Youth Development and Community Engagement; Justin Johns, director of operations for the D.C. LGBTQ+ Community Center; Ryan Bos, executive director of the Capital Pride Alliance; and Bo Belotti, development manager for the community services organization HIPS.
A spokesperson for the mayor’s office didn’t immediately respond to a request from the Washington Blade for comment on whether the mayor and other city officials were taking steps to address the issue of grant funding delays raised at the D.C. Council hearing.
Branch, a special three-part series on mental health crisis response. His reporting was featured on NPR, PBS NewsHour, The Marshall Project, and Slate. He was a producer for KQED News, San Francisco, where he reported and produced sound-rich feature stories, developed, and executed engagement strategy, provided editorial feedback, and mixed pieces for the weekly Bay Curious podcast. Before that he was a producer and reporter at KBIA News in Columbia, Missouri.

Levi earned his bachelor’s degree in journalism from the University of Missouri, and a bachelor’s degree in Spanish, College of Arts and Science. He has won numerous honors and recognition for his work, including: Region 2 Edward R. Murrow Best News Series award for Three Refugees, Three Journeys to California; and second place 2017 Hearst Journalism Awards Radio Competition (reporter).

vows to keep fighting outside the government
By JOE REBERKENNY
The board of the affinity group Gays and Lesbians in Foreign Affairs Agencies (GLIFAA) announced “extraordinary measures,” including a spate of resignations, on Friday to keep in compliance with President Trump’s “Defending Women” executive order.
GLIFAA, an employee resource group that advocates for LGBTQ inclusion, equality, and workplace protections within U.S. foreign affairs agencies, announced that elected board members who were active U.S. government employees stepped down. The group was forced to take the drastic step amid Trump’s attacks on federal workers and efforts to slash spending. In a letter obtained by the Washington Blade, GLIFAA says that its work within the Executive Office will end because of Trump’s “Defending Women from Gender Ideology Extremism and Restoring Biological Truth to the Federal Government” order, but will continue advocating for LGBTQ federal workers through its independent 501(c)(3) nonprofit organization status outside of its former official government capacity.
Executive Order 14168, also known as the “Defending Women” order, prompted this change within GLIFAA. It mandates that federal agencies recognize only two sexes, prohibits the use of gender identity in federal documents, and stops funding for gender-affirming care and any programs promoting “gender ideology.”
In the letter sent on Friday, the organization explained its board members resigned to comply with the recent executive order on LGBTQ rights, but not before appointing an interim board to help make the shift out of the federal government. It also urged any members of the GLIFAA board to remove any work email accounts connected with the organization and switch them to personal
email addresses to avoid any potential retaliation, as well as to pay membership dues to allow the organization to continue protecting LGBTQ federal workers.

Despite these changes to the organization’s structure and ability to work in an official capacity within the government, the message was clear that GLIFAA will adapt to these changes to continue supporting LGBTQ federal workers, as well as other LGBTQ people facing oppression.
“We recognize the deep challenges this moment poses to both our membership and our mission to advocate for human rights, dignity, and equal access to opportunities for all members of our Community,” the letter reads.
“Since 1992, GLIFAA has successfully advocated for policies that reversed discriminatory security clearance denials, secured benefits and accreditation for our spouses and family members, expanded healthcare and insurance coverage to meet the needs of our community, and promoted the advancement of human rights globally. We began this work in 1992 without official Department recognition, and while our activities as an employee organization have ceased for now, our mission to advocate for full legal and social equality for our members and their family members in the U.S. foreign affairs community will continue, albeit under different terms.”
The letter continued, advocating for perseverance amid an administration that has been hostile to the LGBTQ community, especially the trans community.
“In challenging times, the strength and resilience of our community matters more than ever. GLIFAA always has and always will represent all letters of the LGBTQIA rainbow. We are strongest when we stand together. So, we urge you to reach out to other members, uplift your colleagues and friends, and carry forward GLIFAA’s unwavering spirit of resilience, determination, and support for equality — wherever you are.”
This comes days after multiple federal government websites wiped any mention of transgender people, removed mentions of how HIV and other health problems disproportionately impact the LGBTQ community, and information on Civil Rights protections to comply with Trump’s executive order. Some websites affected by this order include formerly non-partisan organizations like the Centers for Disease Control and Prevention, Census Bureau, and National Park Service.
‘Cocktails for a Cause’ fundraiser draws more than 100
By LOU CHIBBARO JR.
| lchibbaro@washblade.com
Organizers of D.C.’s annual LGBTQ Black Pride celebration announced at a Jan. 29 ‘Cocktails for a Cause’ fundraising event that the theme for this year’s celebration is “Black Pride is Freedom.”
Like past years, this year’s Black Pride will take place during Memorial Day weekend from May 23-26 and will be an official event of World Pride, which D.C. is hosting this year.
Just over 100 people turned out for the theme announcement event at the City Club of D.C., which provided the cocktail lounge meeting space free of charge and was donating a percentage of its drink sales to Black Pride, according to Black Pride organizer Kenya Hutton.
Hutton, who serves as CEO and president of the Center for Black Equity, a D.C.-based LGBTQ advocacy group that organizes Black Pride, said the theme was selected in part based on the issues the LGBTQ community is facing in 2025.
“Just looking at how things are going in the world right now, it seems that our safe spaces are in jeopardy,” Hutton told the Washington Blade in recounting what he said at the Jan. 29 event.
“And with the attacks that are happening on the Black community and Black LGBTQ communities, especially on our trans community, coming out with the theme of Black Pride is Freedom is sort of a declaration,” he said.
“It is declaring that we are going to continue being free, we’re going to love how we are freely, love who we want freely, show how we want to be freely,” Hutton said. “We just want to be free and we’re not going back in the closet, we’re not going to go into hiding. We’re going to live out free and out loud unapologetically,” he said.
Hutton said most of this year’s Black Pride events, which include panel discussions and workshops, will take place at the Capital Hilton Hotel.
The Capital Pride Alliance, which organizes most of D.C.’s LGBTQ Pride events and is the lead organizer of this year’s World Pride, states on its website that World Pride events will take place in D.C. from May 17 through June 8.

Among the first of the events will be D.C. Trans Pride, which is scheduled to be held May 17-18, just ahead of Black Pride, which is set to be held May 23-26. A listing of the World Price events can be accessed at worldpridedc.org.

Luxury assisted living apartments located in the former Fairfax Hotel
By LOU CHIBBARO JR. | lchibbaro@washblade.com
An upscale senior and assisted living apartment building located two blocks from Dupont Circle, which is scheduled to hold a grand opening ceremony on Feb. 12, has announced it is “LGBTQ+ friendly.”
A statement released by the new seniors home, called the Inspir Embassy Row, located at 2100 Massachusetts Ave., N.W., says it is proud to have received recognition as a SAGECare Platinum Credentialed Provider from the New York City-based LGBTQ seniors advocacy and training group SAGE.
“To earn this prestigious credential, a minimum of 80 percent of Inspir’s management and non-management staff completed comprehensive training in LGBTQ+ aging cultural competency,” the statement says.
“The program covered crucial topics including historical and contemporary LGBTQ+ struggles, proper terminology usage related to sexual orientation and gender identity, and strategies to address the unique challenges faced by this demographic,” according to the statement sent to the Washington Blade.

Inspir Embassy Row’s general manager, Tim Cox, who is gay and said he lives with his husband just five blocks from the soon to open facility, provided the Washington Blade with a tour of the senior living building. He said it includes 174 apartments, including studio apartments and one and two-bedroom apartments.
Residents have signed up for about 45 of the apartments so far, Cox said, including some LGBTQ residents, who will begin moving in on Feb. 18. He said the upscale building is open to seniors who currently do not need assisted living services as well as those who need different levels of care, including memory loss care.
He said a doctor and nurse practitioner will be among the staff team providing services for residents. Although each of the apartments has a small kitchen, Cox said three meals a day will be served in the building’s large, first floor dining room. The building also includes common areas with spaces for entertainment such as the showing of movies and a large grand piano for visiting performers.
“At Inspir Embassy Row, we’re dedicated to creating an inclusive environment that celebrates the diversity of our residents,” Cox said in the statement released by the building, which is the former home of the Fairfax Hotel.
“This SAGECare certification is a testament to our commitment to providing personalized, compassionate care that respects and honors the identities and experiences of all our residents, including those in the LGBTQ+ community,” Cox said.
He added, “Our goal is to create a home where every resident feels valued, respected and free to be themselves. The SAGECare certification is just the beginning of our journey to set a new standard for inclusive senior living in Washington, D.C.”
But the monthly rent for residents of Inspir Embassy Row will likely place it out of reach for many potential senior residents. Cox said the monthly rent for a one-room studio apartment is $8,100, with the monthly cost of a one-bedroom apartment ranging from $11,500 to about $15,000. A two-bedroom apartment will cost $18,500 per month.
Some of those costs will be covered for residents who have long-term care insurance, Cox said.
Asked if potential residents who can afford the monthly costs at Inspir Embassy Row would be better off staying in their own homes and hiring staff and others to comfortably assist them, Cox said Inspir provides far more than just meals and a place to stay.







When remaining at your own home “you’re isolated, you’re lonely, you don’t have activities,” he said. “When you have people coming to care for you, they’re not there as companions,” Cox said. “So, for this, we give them opportunities. We take them to the Kennedy Center. We have music here on a daily basis.”
Cox added, “We have authors come in. We have speakers that are renowned coming in. Since we’re on Embassy Row, we’ll have ambassadors come in to introduce their country. So, really it is being able to get to know our community better and being social, interactive.”
The statement released by Inspir Embassy Row says the facility will provide “LGBTQ+ specific activities, events, or support groups to allow residents the opportunity to share similar experiences with other residents,” and there will be “partnerships with local LGBTQ+ organizations.”

Lambda Legal, the ACLU, and the ACLU of Maryland, joined by the law firms Hogan Lovells and Jenner & Block, have sued the Trump-Vance administration over its issuance of an executive order banning gender affirming care nationwide for patients younger than 19.
The lawsuit, filed Tuesday in the U.S. District Court for the District of Maryland, seeks “preliminary and permanent injunction preventing the Agency Defendants, including any subagencies of Defendant HHS, from enforcing or implementing the Denial of Care and the Gender Identity Orders.”
PFLAG National and GMLA are also representing the plaintiffs in the lawsuit, seven families with transgender or nonbinary children.

Trump’s executive order last week prohibits health insurers run by the federal government, including Medicaid and TRICARE, from funding medical care for trans and gender diverse youth that is recommended by mainstream scientific and medical organizations like the American Medical Association.
Hospitals throughout the country subsequently suspended or shut down their gender affirming care programs. Those that have acknowledged the move publicly cited the administration’s order, which threatens federal funding and grants for noncompliance.
New York Attorney General Letitia James issued a letter on Monday, signed by a coalition of 22 state AGs, informing hundreds of recipients of federal funding, including healthcare providers, “who were informed that funding cannot be frozen or withdrawn on the basis of providing gender affirming care to minors.”
Likewise, the lawsuit filed by Lambda Legal and the ACLU argues the executive orders are “unlawful and unconstitutional,” first because they seek to withhold federal funds previously authorized by Congress and second because they violate anti-discrimination laws.
The Los Angeles Blade, Southern California’s leading LGBTQ news outlet, this week announced the appointment of a new publisher, Alexander Rodriguez.

The State Department has eliminated references to transgender travelers from its travel advisories.
The International Travel tab that the State Department’s Bureau of Consular Affairs maintains has a section for “LGB Travelers.”
“LGB travelers can face special challenges abroad,” reads the introduction. “Laws and attitudes in some countries may affect safety and ease of travel. Many countries do not recognize same-sex marriage. Many countries also only recognize the male and female sex markers in passports and do not have IT systems at ports of entry that can accept other sex markers. About 70 countries still consider consensual same-sex relations a crime. In some of these countries, individuals who engage in samesex sexual relations may face severe punishment.”

Steven Romo of NBC News and other reporters have noted the same page before President Donald Trump took office used the LGBTQI+ acronym to describe the community. State Department officials with whom the Washington Blade spoke during the Biden-Harris administration routinely used the LGBTQI+ acronym.
Trump since he took office on Jan. 20 has issued a number of executive orders that specifically target trans people.
One directive bans the State Department from issuing passports with “X” gender markers, reversing a policy that took effect in 2022.
Secretary of State Marco Rubio earlier this week issued a waiver that allows the President’s Emergency Plan for AIDS Relief and other “life-saving humanitarian assistance” programs to continue to operate during the freeze on nearly all U.S. foreign aid spending. The waiver does not apply to “activities that involve abortions, family planning conferences” and “gender or DEl ideology programs, transgender surgeries, or other nonlife saving assistance.”
MICHAEL K. LAVERS
Rodriguez has a long background in queer media, business development, and a deep commitment to the Los Angeles community. He has worked as a lead writer and podcast host for Metrosource Magazine and for GED Magazine; content director for FleshBot Gay; and as host and producer for the “On the Rocks” podcast. On the business side, Rodriguez spent years working in business development in the banking industry throughout Los Angeles. He also has an extensive background in event planning and management and has served on the boards of many LGBTQ non-profits. As a TV and radio personality, he has served as emcee for LGBTQ events around the nation.
“I’m excited to bring my diverse media and business experience to the Los Angeles Blade,” Rodriguez said. “We will continue the Blade’s mission of serving as our community’s news outlet of record during these challenging times and work toward building bridges within our community and beyond.”
Rodriguez started in his new role on Monday, Feb. 3.
“We are thrilled to welcome Alexander to the Blade team,” said Kevin Naff, one of the owners of the Los Angeles Blade. “His multimedia and business side
experience will help us grow the Blade in L.A. and continue our commitment to best-in-class journalism serving the LGBTQ community in Southern California.”
Rodriguez becomes the Los Angeles Blade’s second publisher following the unexpected death of founding publisher Troy Masters in December. Masters served in the role for nearly eight years. The community will come together for a celebration of Masters’s life on Monday, Feb. 10, 7-9 p.m. at the Abbey.
“Troy’s legacy is in good hands with Alexander at the helm alongside our new local news editor, Gisselle Palomera,” Naff added.
The Los Angeles Blade, launched in 2017, celebrates its eighth anniversary in March. It is the sister publication of the Washington Blade, founded in 1969, which offers unmatched coverage of queer political news and is the only LGBTQ outlet in the White House press pool and the White House Correspondents’ Association, and the only LGBTQ outlet with a dedicated seat in the White House briefing room. Alexander Rodriguez can be reached at arodriguez@losangelesblade.com FROM STAFF REPORTS

By MICHAEL K. LAVERS | mlavers@washblade.com
MEXICALI, Mexico — Marlon, a 35-year-old man from Guatemala, used the CBP (U.S. Customs and Border Protection) One app to schedule an appointment that would have allowed him to enter the U.S. at a port of entry.
His CBP One appointment was at 1 p.m. PT (4 p.m. ET) on Jan. 21 in the Mexican city of Tijuana that borders San Diego. Marlon at around 11 a.m. PT (2 p.m. ET) on Jan. 20 learned his appointment had been cancelled.
President Donald Trump took office less than two hours earlier.
“We’re stuck,” Marlon told the Washington Blade on Jan. 31 during an interview at Posada del Migrante, a migrant shelter in the Mexican border city of Mexicali that Centro Comunitario de Bienestar (COBINA), a group that serves LGBTQ people and other vulnerable groups, runs.
The Trump-Vance administration’s immigration policies have left Marlon and many other migrants and asylum seekers — LGBTQ and otherwise — in limbo.
Daniela is a 20-year-old transgender woman from Tijuana who has lived at Jardín de las Mariposas, a shelter for LGBTQ migrants and asylum seekers in the city’s Obrera neighborhood, for a month. Jardín de las Mariposas is roughly six miles south of the Mexico-U.S. border.
She told the Washington Blade on Jan. 29 during an interview that she was raped in Hermosillo, the capital of Mexico’s Sonora state, four months ago. Daniela said her roommate and five other people later tried to kill her when they “were drunk and on drugs.”
Daniela, like Marlon, had a CBP One appointment, but it was cancelled once Trump took office.
“I am completely alone both in Tijuana and elsewhere,” said Daniela. “I think the United States is a better option to be able to start over.”
Stephanie, a 25-year-old from El Paraíso, Honduras who identifies as a lesbian, arrived in Tijuana last July and lives at Jardín de las Mariposas.
She told the Blade her family is “very religious,” and she is the “only one in my family who is a member of the [LGBTQ] community.” Stephanie said a cousin in Louisiana agreed to allow her to live with her once she entered the U.S., but she refused once she saw she had cut her hair.
“I felt a bit of freedom once I arrived here in Mexico … and I decided to cut my hair because it was very long,” recalled Stephanie. “One day she did a video call and she saw my short hair and she was like I cannot receive you; I cannot receive you because what example are you going to be to my son.”
Trump, in addition to shutting down the CBP One app on Jan. 20, issued several immigration-specific executive orders after his inauguration. They include:
• Declaring a national emergency on the Southern border
• Suspending the U.S. Refugee Admissions Program
• Ending birthright citizenship under the 14th amendment. (U.S. District Judge John Coughenour, who Ronald Reagan appointed, in a Jan. 23 ruling that temporarily blocked the directive described it as “blatantly unconstitutional.”)
Trump has reinstated the Migrant Protection Protocols program, also known as the “Remain in Mexico” policy that forced asylum seekers to pursue their cases in Mexico.
State Department spokesperson Tammy Bruce on Tuesday said Salvadoran President Nayib Bukele during his meeting with Secretary of State Marco Rubio “agreed to take back all Salvadoran MS-13 gang members who are in the United States unlawfully,” and “promised to accept and incarcerate violent illegal immigrants, including members of the Venezuelan Tren de Aragua gang, but also criminal illegal migrants from any country.” The Department of Homeland Security in a press release notes Tren de Aragua members were on the first U.S. military “flight of criminal aliens” that arrived at the Guantanamo Bay Naval Base in Cuba on Tuesday.
Jardín de Las Mariposas Director Jamie Marín on Jan. 29 told the Blade that Trump’s policies have sparked “a lot of fear.”
She said some of the shelter’s residents who had their CBP One appointments cancelled have either returned to their countries of origin or have found another way to enter the U.S., including with the help of smugglers who are known as “coyotes” in Mexican Spanish. Marín said Jardín de las Mariposas is working with those who have decided to stay in Tijuana to help them secure identity documents and employment.
“Our goal was to be a temporary shelter to move to the United States,” she told the Blade. “Now it’s almost becoming like we’re going to become a permanent shelter until we find another solution for them.”
Susy Barrales is president of Casita de Unión Trans, a trans support group that she founded
in Tijuana in 2019 after she was deported from the U.S.
She told the Blade during a Jan. 30 interview at her office, which is a few blocks from the border, that two migrants who the U.S. deported arrived at Casa de Unión Trans the day before without medications. Barrales, like Marín, said the Trump’s immigration policies have sparked concern in Tijuana.
“He is doing this political campaign,” said Barrales in response to the Blade’s question about Trump’s policies. “I think it is something political, a political strategy that he wants to do, as a way to slow down immigration. This is why he makes these types of racist comments against migrants and against the community.”
The Trump-Vance administration’s decision to suspend nearly all U.S. foreign aid spending for at least 90 days has had a direct impact on Mexican organizations that serve LGBTQ migrants and asylum seekers.

Frida works with upwards of 300 LGBTQ asylum seekers and migrants in Mexico City and in the cities of Monterrey and Tapachula. Sixty percent of Casa Frida’s annual budget comes from U.S. government grants — specifically from the U.S. Agency for International Development, the State Department, and its Office to Monitor and Combat Trafficking in Persons.
Casa Frida Director Raúl Caporal on Monday told the Blade the U.S. on Jan. 24 suspended funding for five of his organization’s initiatives.
A poster inside COBINA’s offices on Jan. 31 contained a QR code that brought migrants to a WhatsApp page that had information about how they could “migrate informed and legally.” The State Department partnered with Partners of the Americas, a Washington-based NGO, on the initiative.
Maky Pollorena, a Mexicali-based activist who works with COBINA, told the Blade the WhatsApp page stopped providing information on Jan. 24. Pollorena also said COBINA and the majority of migrant shelters in Mexico’s Baja California state of which Mexicali is the capital have lost between 50 and 70 percent of their funding.
“All of us who are in Baja California’s border strip are tense,” said COBINA President Altagracia Tamayo.
Marín noted Jardín de las Mariposas’ funding does not come from the U.S. government, but rather from the Transgender Law Center and other NGOs that include AIDS Healthcare Foundation. Baja California Gov. Marina del Pilar Ávila’s administration donated the building in which Jardín de las Mariposas is located. The International Organization for Migration, the U.N. High Commissioner for Refugees, and the Organization for Refuge, Asylum and Migration are also support Jardín de las Mariposas.
Despite this lack of dependence upon U.S. government funding, Marín said the TrumpVance administration’s policies could prove deadly.
“These decisions from the Trump administration are going to cost a lot of lives for the LGBT community, not only here,” she said. “It’s also going to cost a lot of lives in the United States.”

is the monomynous founder and former Creative Director of Team Rayceen Productions. Zar led TRP for more than 10 years and has lived in the Capital region all of his life. The impetus for his recent resignation and the indefinite hiatus of TRP is the new presidential administration.
I’m




• 15 individual units for single occupancy in communal
• 5,300 square feet of shared communal space
• Fully-equipped kitchen with separate dining area
• ADA adaptable units (Americans with Disabilities Act)




Are you excited about WorldPride DC? Really? Then you must know more — or much less — than I do.
As displayed on the WorldPride DC website, festivities begin a little more than three months from now. Click on the “Events” tab and that page lists multiple events, with several of them including information such as the venue and/or a vague synopsis of what will happen.
Who will perform? There is Shakira, whose current world tour was originally going to bring her to D.C. last November, but that was cancelled and her new date is now designated as the Welcome Ceremony for WorldPride DC. I commend her for being an ally to the LGBTQ community, but I’m curious what modifications will be made to her tour set list and if any LGBTQ people will be on stage. Who else will perform during the (recently moved up to) May 17 to June 8 dates? Capital Pride Alliance announced a call for performers on Jan 13.
To be clear, that announcement was made on Jan. 13 of THIS year, slightly four months ahead of festivities beginning. I share that with astonishment. I state everything above and below with varying degrees of annoyance, consternation, frustration, and alarm.
Back in 2021, CPA was eagerly competing to win its bid to host WorldPride 2025. All of the excitement led to the announcement, in November 2021, that it was going to Taiwan. However, in August 2022, it was announced that Taiwan and WorldPride consciously uncoupled, and, in November 2022, it was announced that the proposal of jilted runner-up D.C. had been accepted.
Even with my low expectations, I did not think that timeline would lead to a purportedly international event happening in less than 20 weeks having merely one announced performer, events with TBA venues, and little happening that wouldn’t be unusual for a typical annual Capital Pride celebration.
Perhaps I don’t know enough. Maybe this rollout is typical for festivals and other major events. What is the appropriate comparison? Is it Coachella or Comic-Con? Or is it Carnival or the Olympics? Maybe they are on track with what New York or Sydney did in 2019 and 2023, respectively. Maybe they are waiting, for some reason, to make announcements that may come too late to entice people to attend and participate in WorldPride DC.
Or perhaps I know too much. I know who isn’t booked for WorldPride DC. I know what things could have happened. I know what I’ve heard in meetings and conversations, including Capital Pride’s reluctance to share substantial information or bring in outside experts. I know countless bits of miscellaneous information that cause me trepidation. I have had contact with numerous people, including performers, leaders of organizations, and subcommittee members, and not once has anyone said anything that assuaged my concerns.
Unlike the opening of D.C.’s new LGBTQ community center, WorldPride DC won’t be delayed and is definitely happening this year. What we don’t know is what exactly is happening.
Presumably, Capital Pride had plans when the bid was made in 2021. But maybe they didn’t start planning until the announcement in ‘22. Or perhaps they waited until some time in March 2023, after recovering from traveling to Australia for WorldPride.
When did bookings begin? Perhaps they started with A-list stars and are still working their way through the latter part of the alphabet. Who is likely not available are the activists in other countries who, in addition to planning for travel and lodging, have to contend with passports, visas, and other bureaucratic concerns. Not everyone has the luxury to be spontaneous.
In my former role as Creative Director of Team Rayceen Productions, I was willing to be of service. TRP was ready to partner. We had ideas, but since Capital Pride didn’t express interest, I assumed they had big plans.
Perhaps you know just enough: the infrequency of announcements; the lack of information; the late call for performers; the truncated Capital Pride Heroes nomination process.
Ultimately, the fact that you know so little may be all you need to know.




















is a longtime LGBTQ rights and Democratic Party activist. He writes regularly for the Blade. PETER ROSENSTEIN
An evil SOB with no respect for the truth
We are seeing the hand of Elon Musk, yes, the same Musk who gives the Nazi salute, and tells the Germans to move on and forget about their Nazi past, in every area of our government. He claims to be proud of sleeping in the office President Felon has given him as part of his DOGE work, in the Eisenhower Federal Office Building, and is interfering in every agency, apparently at will. We were told a top Treasury official left the agency after Musk demanded access to the Social Security payment system. He and his lackeys, not government employees, now have access to that, and the entire Treasury Department’s payment system. Guess the Trump coup is nearly complete.
It is said Musk is behind all the confusing memos to federal employees about resigning, and taking private sector jobs. He is interfering in the FAA and now it is reported that he is behind telling FAA employees to retire. President Felon is not just silently going along with all this, he is enabling it. He is doing his own damage by threatening to fire any FBI employee who was involved, in any way, in the cases against him, or his friends. He is clearly creating havoc. His Secretary of Defense just removed NBC, NPR, New York Times, and Politico from offices – replacing them with Breitbart and One America News.
Trump took the occasion of the horrific plane crash over the Potomac, in which 67 perished, to make political hay and blame Obama, Biden, and DEI policies at the FAA. Trump slapped tariffs on Mexico, Canada, and China, and says those countries will pay. He lies! He says everyone will accept higher grocery, oil, and automobile, prices. Calling Trump a moron is polite, he is actually an evil SOB with no respect for the truth.
He is targeting the transgender community in every area of their lives. From receiving appropriate healthcare, to trying to kick them out of the military, where they have served as patriots, with honor, defending our country. He is making them the focal point of his efforts to hurt the LGBTQ community because they are the easy target. If we don’t stand up for them, and stand with them, as members of the LGBTQ community, then we are next. Let us not be fooled by his naming a few gay and lesbian people to his administration. Let us not be fooled because he has the support of the clearly self-loathing Log Cabin Republicans, who support him for their jobs. Why is his gay Treasury Secretary not speaking up for the transgender community? Why is his lesbian spokesperson at the Department of State, not speaking up? We know it’s because they want their jobs, and that is likely the nicest thing I can say about their silence.
Then we have what we once called the free press. Why was it only Kaitlin Collins of CNN who questioned Trump on his outrageous remarks at the press conference after the crash over the Potomac? And where was the free press when Karoline Leavitt, his press secretary, used the terms transgenderism and woke, at her first press conference? Why didn’t they ask her what the term “woke” means to the Trump administration, what it means to President Felon, and acting President Musk? Why is the press not camped out at the door of Jared Kushner and Ivanka Trump, asking them what they think of the Nazi sympathies of their father’s best friend Musk. Asking them if they vaccinated their children, and do they suggest other parents do the same?
Do I sound angry? You bet I am. I am watching all this insanity as an openly gay, Jewish, man. I wrote in my recently published memoir, and actually thought, when I came out at the age of 34 in 1981, that it would all get easier for future generations. Now we are back to a time when young people could again be afraid to come out, because those they thought would speak out for them, are silent. Was I lying to them? We are again reminded of all those signs, SILENCE = DEATH, that were at the early LGBTQ marches. It is still true. The silence of so many who I know, who don’t like what is happening, is deafening. Is the Trevor Project slogan, “It Gets Better,” a lie? We can still overcome. We must all speak out and not go quietly into the night. If we speak out, defend ourselves, our neighbors, our families, we will save our democracy.










MASON ARTIST-IN-RESIDENCE VERSA-STYLE STREET
DANCE COMPANY
Rooted Rhythms
Saturday, Feb. 15 at 8 p.m.
“Los Angeles’ Best Dance Troupe for Hip Hop Empowerment” (LA Weekly)
The Acting Company August Wilson’s
TWO TRAINS RUNNING
Sunday, Feb. 16 at 7 p.m.
One Earth Tour 2025: Warabe
Saturday, Mar. 1 at 8 p.m
A modern take on the ancient art form of taiko drumming
Sunday, Mar. 2 at 7 p.m.
Five-time GRAMMY Award winner
VERSA-STYLE STREET DANCE COMPANY

A Tony Award-winning play set during the civil rights movement



703-993-2787CFA.GMU.EDU


Seeing red: it’s not just for ire toward the president’s Executive Orders. Next week is also Valentine’s Day. Your faithful gay bars and establishments are gearing up (in some cases, literally) for the holiday. Here is a list of just a few options for the LGBTQ+ set.
On Feb. 14, Crush debuts a new event, just in time for the holiday. Meet Grizzly, a monthly Bear Happy Hour. Running 5-8 p.m., Grizzly features not only discounted drinks (50% off drafts and wine, plus lower-priced cocktails), but food: there will be free hot dogs during the evening. Without skipping a beat, later that night is a Valentine’s Day Stop Light Party 10 p.m. with DJs. Dog tags with green, yellow or red sticker so your crush can see if you’re available. There’s no cover for either.
This Valentine’s Day, Bunker is turning tradition on its head with F*CK CUPID, a high-energy celebration for those over the holiday hype. Whether you’re flying solo or just want to skip the clichés, enjoy an unforgettable night with a special performance by a to-be-announced local drag queen and a dynamic set by Miscalculated. With free entry for singles and just a $5 cover for couples, it’s the perfect chance to dance the night away without the romance-themed distractions.
Join District Eagle this Valentine’s Day for Leather Lovers Gear Night, an inclusive event for all members of the leather community. DJ Jason James will provide the beats throughout the night, and guests wearing gear can enjoy 10% off drinks until midnight. Whether you’re single, taken, or in a situationship, everyone is welcome to celebrate in a welcoming, gear-friendly environment.
Nine is also launching a new event, titled Single Mingle, a singles mixer, the event will rotate theme for dif-
By EVAN CAPLAN



fering tastes. This first event takes place on Feb. 13, 7-9 p.m., upstairs, for those interested in dating queer men. Tickets are $15 and include a complimentary first drink plus ice breakers. On Thursday, Feb. 27, along with DC Gay Girls+, Nine will host a Single Mingle event for those interested in dating in the Sapphic community.

Additionally, Uproar will host a “Cupid Undies” event on Feb. 13 with cocktail specials; Licht is offering a “Date Night” special that includes two cocktails, two glasses of Champagne, and a cheese board for $35; and gayowned Wunder Garten’s event on Feb. 14 is apres-ski themed with drinks like Love Potion and Cupid’s Arrow.



By MIKEY ROX
Put a little love in your heart. That’s what Jackie DeShannon encouraged with her 1969 hit song of the same name, and it’s never been more appropriate than in the context of our current state of affairs. Mute the vitriol this Valentine’s Day and concentrate on what really matters – those you love and who love you back.
Sniffies? You’ll put the site on hold after a whiff of Gucci Guilty Love Edition on the nape of his neck – featuring captivating notes of juniper oil, orange flower absolute and aphrodisiatic Ambrofix – which one review claims to “make your brain sparkle like a fine Champagne.” Cheers to that. $25-$133, FragranceNet.com
Sweet dreams are on the docket when you rest your head on the Hunky Burning Love fauxsuede square pillow printed with illustrations of shirtless himbos pining for your affection. An exercise in fantasy more than reality, but it beats sitting alone at a bar getting no attention at all. $30, ThePillowTopShop.com
Love Deck
What’s in the cards for your love life in 2025? Fuck around and find out with astrologist Lisa Stardust’s 70-card Love Deck, a tarot set of short spells, meditations and rituals designed to conjure enough love, passion, clarity and confidence to make Potion No. 9 jealous. $13, Amazon.com
‘Making the Case for Equality’
We’ll continue to fight the good fight over the next four years and beyond – perhaps harder than ever – and Lambda Legal’s “Making the Case for Equality,” a detailed half-century history of our hard-won judicial victories, is a solid reminder of how far we’ve come in the war for LGBTQ+ rights. $45, Amazon.com
Lola Blankets
Schedule an at-home streaming marathon of this year’s Best Picture noms before the big night – there’s a lot to love in 2024’s Oscar picks – and the coziest way to settle in is all snuggled up in the squishiest Lola blankets, reminiscent of the adorable ripples of the cutest Shar Pei. Pick up a couple for the cuddle puddle. $109-$299, LolaBlankets.com
Asa Akira x Cake Life Cookies
Cue the collaboration you didn’t see coming: Adult film star Asa Akira teams up with award-winning trans-owned bakery Cake Life Bake Shop for its sweet-and-spicy Conversation Heart Sugar Cookies, featuring Akira’s XXX-tra special curated box decorated with NFSW phrases like “Cowgirl,” “Cream Pie,” and the ever-subtle “Anal” – that are sure to leave mouths agog at your Gaylentine’s get-together. $19-$21, CakeLifeBakeShop.square.site
Mind Games Candles
Since the late 1990s, the Backstreet Boys have implored us to quit playin’ games with our lovers’ hearts, which is probably why we play mind games instead – and now they come in luxury scents like Jasmine Milk, Tobacco Tonka Bean and Cherry Sandalwood, so you can enjoy mood lighting with your gaslighting. $135, MindGamesFragrance.com
Delysia Chocolates
Inspired by Greek Goddess-of-Love Aphrodite, Delysia Chocolatier’s 16-piece, limited-edition truffle collection includes four each of symbolic Passion (almond-honey-fig), Adoration (raspberry-rose petal-hibiscus), Unity (pomegranate-strawberry), and Love (spiced wine-berry) bite-size chocolates rich enough for savoring and abundant enough for sharing. $60, Delysia.com
Variety is the spice of life in Thoughtfully Gourmet’s Whiskey-Infused DIY Hot Sauce Kit that combines your favorite cereal spirit with high-quality global ingredients, like Mexican hot peppers, to create sophisticated flavor experiences of varying Scoville heat levels, handsomely housed in fancy decanters. Recipe book, spices and seasonings included; alcohol and antacids are not. $20, Amazon.com
(Mikey Rox is an award-winning journalist and LGBTQ lifestyle expert whose work has been published in more than 100 outlets around the world. Connect with Mikey on Instagram @mikeyroxtravels.)


























By TINASHE CHINGARANDE
Friday, February 07
“Center Aging Friday Tea Time” will be at 2 p.m. on Zoom. This is a social hour for older LGBTQ adults. Guests are encouraged to bring a beverage of choice. For more details, email adam@thedccenter.org.
GoGayDC will host “First Friday LGBTQ+ Community Social in the City” at 7 p.m. at P.F. Changs. This event is ideal for making new friends, professional networking, idea-sharing, and community building. This event is free and more details are available on Eventbrite.
Saturday, February 08
GoGay DC will host “LGBTQ+ Community Brunch” at 11 a.m. at Freddie’s Beach Bar & Restaurant. This fun weekly event brings the DMV area LGBTQ+ community, including allies, together for delicious food and conversation. Attendance is free and more details are available on Eventbrite.
“Fashion Freeway” will be at 11 a.m. at the DC Center for the LGBT Community. Guests will have the opportunity to check out the clothing closet. Clothes, shoes, accessories, and other items will be available. For more details, email info@thedccenter.org.
Sunday, February 09
GoGay DC will host “LGBTQ+ Community Dinner” at 6:30 p.m. at Federico Ristorante Italiano Freddie’s Beach Bar & Restaurant. Guests are encouraged to come enjoy an evening of Italian-style dining and conversation with other LGBTQ folk. Attendance is free and more details are available on Eventbrite.
GoGay DC will host “LGBTQ+ Coffee and Conversation” at 12 p.m. at As You Are. This event is ideal for making meaningful new connections and informal community building. Or just to unwind and enjoy the group happy hour. Fabulous people from all over the world are expected. Nametags will be provided. This event is free to attend and more details are available on Eventbrite.
Monday, February 10
“Center Aging Monday Coffee & Conversation” will be at 10 a.m. on Zoom. This is a social hour for older LGBTQ adults. Guests are encouraged to bring a beverage of choice. For more details, email adam@thedccenter.org.
Genderqueer DC will be at 7 p.m. on Zoom. This is a support group for people who identify outside of the gender binary. Whether you’re bigender, agender, genderfluid, or just know that you’re not 100% cis. For more details, visit www.genderqueerdc.org or Facebook.
Tuesday, February 11
Coming Out Discussion Group will be at 7 p.m. on Zoom. This group is a safe space to share experiences about coming out and discuss topics as it relates to doing so. By sharing struggles and victories the group allows those newly coming out and who have been out for a while to learn from others. For more details, email supportdesk@ thedccenter.org.
Trans Support Group will be at 7 p.m. on Zoom. This group is intended to provide emotionally and physically safe space for trans* people and those who may be questioning their gender identity/expression to join together in community and learn from one another. For more details, email supportdesk@thedccenter.org.
Job Club will be at 6 p.m. on Zoom. This is a weekly job support program to help job entrants and seekers, including the long-term unemployed, improve self-confidence, motivation, resilience and productivity for effective job searches and networking — allowing participants to move away from being merely “applicants” toward being “candidates.” For more information, email centercareers@thedccenter.org or visit www.thedccenter.org/careers.
The DC Center’s Fresh Produce Program will be held all day at the DC Center for the LGBT Community. People will be informed on Wednesday at 5 p.m. if they are picked to receive a produce box. No proof of residency or income is required. For more information, email supportdesk@thedccenter.org or call 202-682-2245.
Virtual Yoga with Charles M. will be at 7 p.m. on Zoom. This is a free weekly class focusing on yoga, breath work, and meditation. For more details, visit the DC Center for the LGBT Community’s website.
CAMP Rehoboth Theatre Company will kick off its 2025 season with its first-ever poetry jam followed by a full-stage production of “5 Lesbians Eating a Quiche” on Friday, Feb. 21 at 5 p.m. at CAMP Rehoboth’s Elkins-Archibald Atrium.
CAMP Rehoboth Poetry Jam Poets / Performers include: Debbie Bricker, Kari Ebert, Shelley Blue Grabel, Lavance John, Vanita Leatherwood, Syd Linders, Ellie Maher, Jane Miller, Gwen Osborne, Coco Silveira, Guillermo Silverira, Laura Unruh, Paul Unruh, and Sherri Wright.

CAMP Rehoboth Theatre Company will kick off its 2025 season on Feb. 21. (Washington Blade file photo by Michael Key)
“5 Lesbians Eating A Quiche,” which will run from March 7-9 debuted at CAMP Rehoboth in fall of 2022, and features returning cast members Karen Laitman, Kelly Sheridan, Gwen Osborne, Darcy Vollero, and Shelley Kingsbury, and is directed by Teri Seaton. The absurdist comedy follows the Susan B. Anthony Society for the Sisters of Gertrude Stein having their annual quiche breakfast in 1956. Winner of the 2012 NYC International Fringe Festival as Best Overall Production, “5 Lesbians Eating A Quiche” is a tasty recipe of hysterical laughs, sexual innuendos, unsuccessful repressions, and delicious discoveries. For more information, visit CAMP Rehoboth’s website.


















‘Waitress,’
By PATRICK FOLLIARD
For theatergoers seeking to mark Valentine’s Day with live music, love, and friendship, the DMV offers some new spins on traditional themes.
Poised to make its regional debut at Olney Theatre Center, Sara Bareilles’s hit musical “Waitress” (Feb.13-March 30) may not seem like a usual love story, but it’s a love story nonetheless.

“It’s about learning to love and value yourself,” says MALINDA who plays Jenna, the show’s titular server/baker with aspirations to bake prize-winning pies and change her life. “It’s also about sisterhood. From the start, the women involved in the show decided to be there for each other onstage and off, and it shows. For anyone with girl group love in their lives, this is an especially good show to see.
“Jenna doesn’t get a lot of satisfaction out of her primary partnership. Along with self-love she explores the antithesis of that — partner violence. Our director [Marcia Milgrom Dodge] took the lesson of community support and community love to heart.”
Prior to coming out as bisexual in 2022, MALINDA considered herself more of a “quiet queer.” However, the inspiration derived from Irish music (“music of the oppressed”), which she’s famed for singing on TikTok, compelled her to go public.
She didn’t always believe her queerness to be special: “For me,” MALINDA says, “it was like saying my eyes are hazel. There wasn’t much to celebrate. But then I realized there were missing voices in my community. Felt like the right thing to do, and it’s been one of the great blessings of my life.”
Six years ago, after her Helen Hayes Award-winning turn in “Once,” MALINDA took a break from musical theater. She needed time to age into dream parts, and one of those roles was Jenna. She recalls, “Going back to theater was prominently featured on my vision board, so when Marcia asked me to commit to ‘Waitress,’ I happily agreed.”
For her, Valentine’s Day is an opportunity to reach out and tell friends, family, and, of course, romantic partners, just how much you love them.
And she adds “that’s exactly how I plan to celebrate.”
D.C.’s delightful Holly Twyford is spending Valentine’s Day working at the Folger on Capitol Hill. She’ll be on stage, her wife will be in the audience, and depending on the length of the program, they’ll go out to dinner afterward.
For four performances, the multi-Helen Hayes award-winning actor is serving as narrator for “The Love Birds” (Feb. 14-16), a new Folger Consort work that blends medieval music with a world-premiere composition by acclaimed composer Juri Seo and readings from Geoffrey Chaucer’s “A Parlement of Foules” by Twyford.
Standing behind a podium, she’ll read Chaucer’s words (translated from Middle English and backed by projected slides in the original language), alternating with music played on old and new instruments.
“The new music is kind of dissonant with the sounds of birdcalls and nature sounds, painting a picture of what’s going on in Chaucer’s poem that’s beautiful and funny. Chaucer describes the male eagles pleading for the hand of the female eagle. Chaucer seems almost unwittingly feminist when he has the female eagle ask her eagle suitors to give her a year to think about it.”
GALA Hispanic Theatre in Columbia Heights presents “Fuenteovejuna” (through March 2), a timely production staged by out director José Luis Arelleno. Penned in 1613, this work from the Spanish Golden Age ranks among playwright Lope de Vega’s most performed plays.
It’s about tyranny and love, Arellano explains. Within Lope de Vega’s timely tale of brutish power lies an intense love story. In fact, at the top of the show, four characters, two males and two females play a game. What is love? One of the players asserts that love doesn’t exist, while the others disagree. It’s a charming way to kick off the play.
The celebrated director isn’t one to telegraph messages, preferring audiences think for themselves. That said, he does, of course, make strong directorial choices: “If I have to choose between love or war, it’s more important to talk about love. For me, it’s a revolution.”
And apropos of a Valentine’s Day date, GALA’s production of “Fuenteovejuna” (performed in Spanish with English surtitles) is imbued with live music and verse, an important part of any romantic experience, adds David Peralto, the production’s poetry and verse consultant as well as Arellano’s longtime partner.
The busy Spain-based couple will celebrate Valentine’s Day in Seville and couldn’t be happier. Arellano describes Seville as the most romantic city in the world.
















By JOHN PAUL KING
Even in a time when it has been well established that an animated film is not necessarily meant for children, you might expect one with the title “Memoir of a Snail” to be something soft, sweet, and whimsical enough to be suitable for even the youngest of toddlers – but you can’t judge a film by its title, any more than you can a book by its cover.
One of 2024’s most well-received films, animated or otherwise, this deceptively adorable feature from Australian animator Adam Elliott certainly fits part of the above description (the “whimsical” part), but it could only be considered a children’s movie by someone who still thinks “cartoons” are for kids. Elliott – whose 2003 film “Harvie Krumpet” won the Oscar for Best Animated Short – is a filmmaker who uses animation (or more specifically, stop-motion “claymation”) to tell semi-autobiographical stories, often about characters based on his own family and friends, and while his visual style might be cute enough to engage your toddler, the content of his narratives is unmistakably tailored for adults.
In this case, that narrative is centered on – and told in flashback by – one Grace Prudel (voiced as an adult by “Succession” star Sarah Snook, and as a child by Charlotte Belsey and Agnes Davison), a girl who grows up in 1970s Melbourne with a twin brother named Gilbert (Mason Litsos/Kodi SmitMcPhee) under the care of their father, a former French animator (Dominique Pinon) with a fondness for roller coasters. When he dies and leaves them without support, the deeply bonded Grace and Gilbert are taken into the foster system and sent to live with families on opposite sides of the country. Grace, whose “swinger” foster parents often leave her on her own, struggles with isolation and loneliness, while Gilbert suffers under the tyrannical rule of a fundamentalist religious couple who exploit all their children as free labor. Eventually, Grace crosses paths with Pinky (Jacki Weaver), an elderly free spirit who takes on the role of mentor and helps her endure a number of hardships, including a disastrous wedding engagement and her continued separation from Gilbert; depressed, overweight, and increasingly seeking refuge with her collections of snails,
romance novels, and guinea pigs – all of which serve as both consolation and distraction from her seemingly impossible dream of following in her father’s footsteps to make animated films – it is her bond with Pinky that may finally provide her with the lifeline to keep her hope alive.
Striking a delicate balance between sentiment and savvy, Elliott’s film – his first feature effort since 2009’s “Mary and Max” – bridges the gap expertly with just enough satirical exaggeration to avoid being maudlin, yet keeps its eye on the redemptive prize (despite the occasional Dickensian twist) by treating Grace with the kind of empathy that can only be achieved by putting the audience completely into her shoes. Without spoilers, we watch as she goes through multiple quirky-yet-relatable setbacks, reinforcing the connection with our own inner misfit by conjuring familiar (and potentially unifying) feelings of inadequacy and leading us, inevitably, to forgive ourselves for our perceived shortcomings.
Visually, “Memoir of a Snail” evokes memories of many other stop-motion efforts, contrasting the inherent “cuteness” of its style with the less-comforting content of its storyline. Resembling a tried-and-true “Wallace and Gromit” film (such as fellow Oscar-nominee “Vengeance Most Foul”) but decidedly more focused on the inner lives of its characters, it blends and contrasts a familiar and traditional form with an emotional honesty that disarms our cynicism. Mixed with its comforting whimsy is an acknowledgement of life’s dark corners, a frank awareness that, sometimes, loss and sorrow happen and there’s nothing to be done but to go through them – there are no fantastical inventions to ease Grace’s path, no tongue-in-cheek capers that can set things right and restore her world to some kind of happy status quo; like the rest of us, she must work through the darkness not to get back to the way things were, but to arrive at a place where new things are possible – where the grief and sorrow that are inevitably woven into our life can be weathered and overcome, even if they can’t be avoided.
As to that grief and sorrow, “Memoir of a Snail” touches on the universal;

Grace’s struggles with loss and loneliness, the disappointments, humiliations, and outright betrayals she confronts, all hit close to home – the loss of loved ones, the loneliness of not fitting in, the trauma of being bullied and abused – and there are no easy answers to getting through them.
Yet melancholy as its tone may often feel, Elliott’s movie defies its own gravity with a wicked sense of humor and a sharp knack for commentary on the quirks and foibles of human behavior. Despite the grimness into which it sometimes must descend – which includes the depiction of shock treatment used for “conversion therapy” by Gilbert’s homophobic foster family – it manages to maintain a light-hearted attitude, buoyed by a keen (and often ironic) sense of humor and an embrace of the inescapable absurdities of life, and emerge not only with acceptance but with hope – with a little help, that is, from our friends.
It’s this message that infuses “Memoir” with such a sense of humanity; it is through the special bonds she finds that Grace endures – and not only the ones she shares with her beloved snails. The
heart of the movie beats through her friendship with Pinky, a fellow “misfit” with the wisdom and kindness to renew her faith in life, and it’s that warmth and humanity that takes a tale of hardship and emotional suffering and turns it into one of the year’s most delightful movies.
Visually lovely, with an array of memorable voice performances and a delicious balance of humor ranging from silly to the macabre, “Memoir of a Snail” may not have the Disney appeal – nor the subject matter – to make it a good choice for children, but it has the candor and willingness to explore the darker places in our lives, the “sacred wounds” that give our lives meaning, and the power of love to keep us in the light.
Nominated for the Best Animated Feature Oscar, Elliott’s film is now streaming via multiple VOD platforms – and as much, if not more, worth your attention as any of the live action films competing in the other categories. After all, a movie about the power of kindness to help us endure difficult times is something most of us could probably use, right about now.

Memoir ‘Frighten the Horses’ a long but essential read
By TERRI SCHLICHENMEYER
Finding your own way.
It’s a rite of passage for every young person, a necessity on the path to adulthood. You might have had help with it. You might have listened to your heart alone on the quest to find your own way. And sometimes, as in the new memoir, “Frighten the Horses” by Oliver Radclyffe, you may have to find yourself first.
If you had observed Oliver Radclyffe in a random diner a few years ago, you’d have seen a blonde, bubbly, but harried mother with four active children under age seven and a distracted husband. You probably wouldn’t have seen trouble, but it was there.
“Nicky,” as Radclyffe was known then, was simmering with something that was just coming to the forefront.
As a young child, Nicky’d been raised in comfort in a family steeped in genteel British wealth, attended a private all-girl’s school, and never wanted for anything. She left all that behind as a young adult, and embraced the biker lifestyle and everything it entailed. The problem now wasn’t that she missed her old ways; it was that she hated life as a wife and mother. Her dreams were filled with fantasies of “exactly who I was: a man on a motorbike, in love with a woman.”
But being a man? No, that wasn’t quite right.
It took every bit of courage she had to say she was gay, that she thought constantly about women, that she hated sex with men. When she told her husband, he was hurt but mostly unbothered, insisting that she tell absolutely no one. They could remain married and just go forward. Nothing had to change.
But everything had already changed for Nicky.
Once she decided finally to come out, she learned that friends had already suspected. Family was supportive. It would be OK. But as Nicky began to experiment with a newfound freedom to be with women, one thing became clear: having sex with a woman was better when she imagined doing it as a man.
In his opening chapter, author Oliver Radclyffe shares an anecdote about the confusion the father of Radclyffe’s son’s friend had when picking up the friend. Readers may feel the same sentiment.
Fortunately, “Frighten the Horses” gets better — and it gets worse. Radclyffe’s story is riveting, told with a voice that’s distinct, sometimes poker-faced, but compelling; you’ll find yourself agreeing with every bit of his outrage and befuddlement with coming out in a way that feels right. When everything falls into place, it’s a relief for both author and reader.
And yet, it’s hard to get to this point because this memoir is just too long. It lags where you’ll wish it didn’t. It feels like being burrito-wrapped in a heavy-weighted blanket: You don’t necessarily want out, but you might

get tired of being in it.
Still, it remains that this peek at transitioning, however painful, is essential reading for anyone who needs to understand how someone figures things out. If that’s you, then consider “Frighten the Horses” and find it.
‘Frighten the Horses: A Memoir’
By Oliver Radclyffe
c.2024, Roxane Books/Grove Atlantic | $28 | 352 pages












LGBTQ youth services organization holds fundraiser at Shakers
(Washington









Creating a home you can adore in the nation’s capital
By SCOTT BLOOM
As Valentine’s Day approaches, our thoughts often turn to love. While we may think of candlelit dinners or romantic gestures, love extends beyond relationships—it’s about the spaces we inhabit and how we nurture our connection to them. Loving where you live can have a profound impact on your well-being, and for renters in Washington, D.C., transforming an apartment into a cherished home is not only possible, but also can feel essential.

Washington, D.C., offers a vibrant lifestyle, but it can also pose challenges for renters. High costs, stressful work environments, limited space, and the very nature of urban living might make it harder to settle in. However, with some thoughtful adjustments, you can turn your rental into a space you love. Let’s explore how to create a home that’s a sanctuary, not just a stopover.
One of the first steps to loving where you live is making it feel uniquely yours. Although renting may come with restrictions, there are plenty of ways to customize your apartment:
• Add Color: Use removable wallpaper or peeland-stick decals to introduce vibrant or calming hues. Area rugs are another excellent way to bring warmth and character to any room.
• Display Your Story: Showcase meaningful art, family photos, or souvenirs from your travels. Gallery walls can make even a small space feel personal.
• Lighting Matters: Replace harsh overhead lighting with floor or table lamps to create a cozy ambiance. Use LED bulbs to save energy and customize brightness levels.
City living can impose limited square footage and multifunctional furniture is your best friend. Look for pieces that serve dual purposes:
• A storage ottoman can double as seating.
• Fold-out tables save space while offering dining or work surfaces when you need them.
• A quality sofa bed is perfect for accommodating guests
Bringing nature indoors can instantly uplift your mood and enhance your living space:
• Low-Maintenance Options: Snake plants,

Beyond your apartment, Washington, D.C., is a city rich in experiences that make life here unique. Embracing the D.C. lifestyle can deepen your connection to where you live. Here are a few affordable and distinctly D.C. activities to enjoy this Valentine’s Day month:
• The United States Botanical Garden: Even though it is the middle of winter, the Conservatory on the grounds of the U.S. Capitol is a wonderful place to get out of the cold. And a bonus - it is the time of year when orchids are in bloom. Enjoy a touch of a tropical environment right in downtown DC.
• Kennedy Center’s Millennium Stage: Enjoy free performances showcasing local and international talent. Every day, usually at 6 p.m., you can see artists from around the world in the central hall at the Kennedy Center. And all you have to do is get there in time! Check out the entire program here: https://www.kennedy-center.
org/whats-on/millennium-stage
2. Taste D.C.’s Diverse Cuisine:
SCOTT BLOOM is owner and senior property manager of Columbia Property Management. For more information and resources, go to www. ColumbiaPM.com

pothos, and succulents thrive with minimal care.
• Vertical Gardens: If floor space is limited, consider wall-mounted planters.
• Window Sills: Herbs like basil or mint not only look and smell good, they are useful for cooking.
Think about how you use your apartment and design dedicated areas:
• Work Corner: With remote work becoming increasingly common, invest in a comfortable chair, desk, and good lighting.
• Relaxation Spot: A corner with a plush chair, blanket, and books can be your go-to for unwinding.
• Entertaining Area: Even small spaces can shine with the right setup for hosting, such as a stylish bar cart or foldable chairs.
A clutter-free and clean apartment naturally feels more inviting:
• De-clutter quarterly, donating or discarding items you no longer use.
• Use storage systems to stash things away you do not need regularly
• Add seasonal touches like new cushions or throws to keep your space feeling fresh.
• Invest in quality cleaning tools to make upkeep easier.
• Sample global flavors at Union Market. https:// unionmarketdc.com
• Grab a half-smoke from Ben’s Chili Bowl, a true local original, on U Street, H Street, and other locations citywide.
3. Embrace the Outdoors:
• Walk or bike the Mount Vernon Trail along the Potomac River; the Capitol Crescent Trail on the west side, and the newer trail, the Metropolitan Branch Trail that runs from Union Station to Silver Spring.
• Visit Malcolm X Park (also known as Meridian Hill Park) for its cascading fountains, lively drum circles, snow ball fights, and more!

4. Dive Into History:
• Tour the lesser-known exhibits at the Smithsonian Anacostia Community Museum, the National Museums of Asian or African Art, and the incredible Renwick Gallery of American Art op-
posite the White House.
• Explore the Frederick Douglass National Historic Site for a deeper understanding of D.C.’s role in history. https://www.nps.gov/frdo/index.htm
5. Enjoy Affordable Culture:
• Attend pay-what-you-can nights at local theaters like Studio Theatre, Woolly Mammoth Theatre Company, or Theatre J located in the Jewish Community Center at 16th Street and Q Streets, NW.
• Take advantage of free museum access yearround, from the National Gallery of Art to the Hirshhorn Museum.
Building a Life You Love
Loving where you live isn’t just about the walls that surround you—it’s about the life you create within them. By personalizing your apartment and immersing yourself in the unique experiences D.C. offers, you’ll better foster a personal sense of belonging and joy. This Valentine’s Day, remember to nurture not only your relationships, but also your relationship with your home and your city. After all, love begins at home.










































MASSAGE FOR MEN

Private studio near Rosslyn/ Courthouse, weekends (Fri-Mon), 12-9. Text Gary @ 301-704-1158 or visit www.mymassagebygary.com
BUYING JEWELRY/ESTATES
CASH FOR ESTATES
Moving? Downsizing? One item to Whole Estate? Gold Jewelry, Sterling Silver, Quality Glass, Some Furniture, Etc. TheAtticLLC.com
Gary Roman: 301-520-0755 CLEANING
Residential & Commercial Cleaning, Reasonable Rates, Free Estimates, Routine, 1-Time, Move-In/Move-Out 202-234-7050 or 202-486-6183

COUNSELING FOR LGBTQ
People. Individual/Couples counseling with a volunteer peer counselor. GMCC, serving our community since 1973. 202-580-8661 gaymenscounseling.org No fees. Donation requested.

Local licensed company with over 25 years of experience. Specializing in bathrooms, kitchens & all interior/exterior repairs. Drywall, paint, electrical, wallpaper, roofing & siding. Trevor 703-303-8699
ADOPTION,
legal services. Catelyn represents LGBTQ clients in DC, MD & VA interested in adoption or ART matters.
Law Offices, Slattery Law, LLC. 240-245-7765
Catelyn@ModernFamily Formation.com
KASPER’S LIVERY SERVICE

Since 1987. Gay & Veteran Owner/Operator. Lincoln Nautilus! Proper DC License & Livery Insured. www.KasperLivery.com 202-554-2471


SUPERIOR COURT OF THE DISTRICT OF COLUMBIA PROBATE DIVISION 2025 NRT000001
Harry Carter Kelly, Name of Deceased Settlor NOTICE OF EXISTENCE OF REVOCABLE TRUST
Harry Carter Kelly whose address was 4225 Colorado Ave. NW, Washington, DC 20011 created a revocable trust on August 15, 1997, which remained in existence on the date of his death on 01/31/2024, and Bernice G. Kelly, whose address is 4225 Colorado Ave. NW, Washington, D.C. 20011 is the currently acting trustee, hereinafter the Trustee. Communications to the trust should be mailed or directed to c/o Miroslav Nikolov, Esq. at 7100 Columbia Gateway Drive, Suite 190, Columbia, MD 21046. The Trust is subject to claims of the deceased settlor’s creditors, costs of administration of the settlor’s estate, the expenses of the deceased settlor’s funeral and disposal of remains, and statutory allowances to a surviving spouse and children to the extent the deceased settlor’s residuary probate estate is inadequate to satisfy those claims, costs, expenses, and allowances.
Claims of the deceased settlor’s creditors are barred as against the Trustee and the trust property unless presented to the Trustee at the address provided herein on or before 7/31/2025 (6 months from the date of first publication of this notice). An action to contest the validity of this trust must be commenced by the earliest of (1) 1/31/2025 (one year from the date of the deceased settlor) or (2) 7/31/20225 (6 months from the date of first publication of this notice) or (3) ninety days after the Trustee sends the person a copy of the trust instrument and a notice informing the person of the trust’s existence, the Trustee’s name and address, and the time allowed for commencing a proceeding.
The Trustee may proceed to distribute the trust property in accordance with the terms of the trust before the expiration of the time within which an action must be commenced unless the Trustee knows of a pending judicial proceeding contesting the validity of the trust or the Trustee has received notice from a potential contestant who thereafter commences a judicial proceeding within sixty days after notification. This Notice must be mailed postmarked within 15 days of its first publication to each heir and qualified beneficiary of the trust and any other person who would be an interested person within the meaning of D.C. Code, sec. 20-101(d).
Date of first publication: January 31, 2025 /s/Bernice G. Kelly, Trustee, 443-393-7696
A True Test Copy /s/Nicole Stevens, Register of Wills.

TALL, DECENT LOOKING, White male ISO all-American looking white male, well-built & hung, ready to be a total slave for Daddy. You must behave, obey, and follow Daddy’s orders, or you will be punished. Interested? Call or text Daddy, 24 hours a day. Sincere replies only. 240-457-1292
Swedish, Massage or Deep Tissue. Appts. Low Rates, 24/7, In-Calls.




